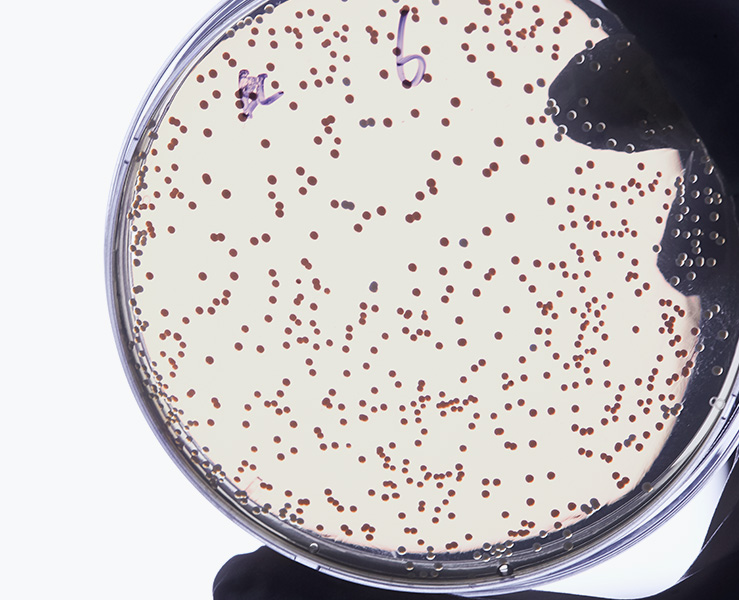

BUSINESS AREA
Probiotics
Core Benefit
From Human, For Human
Probiotics
Supply
우리는 1999년 이래로 건강을 증진시키는 비피도박테리움 균주들에 대한 연구 개발에 주력해 왔습니다. 250편 이상의 관련 과학 논문과 80건의 특허는 비피도가 마이크로바이옴 업계에서 가장 뛰어난 경험과 전문지식을 보유한 최고 반열의 기업임을 입증해 주고 있습니다.
Raw Material
Human Originated Probiotics
우리는 인간의 건강을 증진시키는 관건은 우리의 인체 내부에 있다는 사실을 알고 있습니다. 우리가 생산하고 있는 모든 프로바이오틱스 원료는 인체로부터 나온 것들이며 따라서 우리의 몸에 가장 잘 맞습니다.

ODM Service
Customer Satisfying Product
우리의 헌신적인 뒷받침은 제품을 개발단계에서 끝나는 것이 아닙니다. 우리는 또한 여러분의 자체 브랜드에 대한 여러분의 고객들의 만족도에 대해서도 논의할 준비가 되어있습니다.
우리의Stress-Free Tecnology는 모든 제조 공정을 무산소 환경이 될 수 있도록 하여 절대혐기성인 비피도박테리움 제품들이 최상의 품질을 가질 수 있도록 보장합니다.
See ManufacturingApplicated
Brand
지근억비피더스
고객 건강을 최우선의 가치로 생각하며 30년의 인체 장내 미생물 연구성과를 100% 인체에서 유래한 사람유산균에 담아 사람 본연의 건강을 위한 인체 친화적 브랜드

비피도랩
사람에서 얻은 사람유산균으로, 건강하고 아름다운 사람의 피부를 연구하고 In&Out Beauty Therapy를 제공하는 마이크로바이옴 뷰티 브랜드

